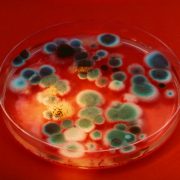

Schimmeltest im Pferdestall – Schimmel im Stall selbst messen
Schimmeltest im Pferdestall und Schimmel selbst messen
Wenn ein Pferd ständig Probleme mit Husten oder verminderter Leistungsfähigkeit hat, kann eine schlechte Stallluftqualität die Ursache sein. Wenn sich die Verdachtsmomente für Schimmel als Ursache der gesundheitlichen Tierprobleme erhärten, kann man einen Gutachter mit einem Schimmeltest für die Luft im Pferdestall beauftragen. Die Kosten für einen gutachterlichen Schimmeltest sind allerdings beträchtlich. Schnell kommen dabei mehrere hundert Euro zusammen. Ein negativer Befund bei dem Schimmeltest durch den Gutachter erfreut zwar den Tierhalter. Auf den Kosten indes wird er aber wahrscheinlich sitzen bleiben – und die Ursache für die gesundheitlichen Probleme beim Tier sind außerdem immer noch nicht gefunden.
In diesem Beitrag stellen wir den Schimmeltest MYKOFUND für den Pferdestall zum selbst machen vor. Mit diesem Schimmeltest kann man prüfen, ob ein Pferdestall übermäßig mit Pilzen belastet ist und ob diese Belastung durch „Stall-typische“ oder „Stall-untypische“ Pilze hervorgerufen wird. Der Schimmeltest für den Stall stellt fest, wo die Quellen der Stallverunreinigungen zu suchen sind und gibt Empfehlungen zur Quellenbeseitigung.
Der sedimentierte Stallstaub birgt viel Information
Die Staub- und Schimmelbelastungen in Pferdeställen sind naturgemäß sehr großen Schwankungen unterworfen. Stallluftqualitätsüberprüfungen mit Luftkeimsammelgeräten sind deshalb immer nur eine kurze Momentaufnahme. Eine solche kann natürlich kein verlässliches Bild der längerfristigen Belastungssituation in einem Stall zeichnen. Siehe heirzu auch https://www.advisan.net/schimmelpilze-in-der-raumluft-messen/. Materialprüfungen auf Schimmel z.B. im Tierfutter oder in der Einstreu sind relativ aufwändig und bei systematischer Herangehensweise fast genauso kostenintensiv. Futtermittelanalysen bilden überdies immer auch nur die hygienische Situation in einer ganz bestimmten Futtercharge ab. Was mögliche Auswirkungen einer verpilzten Futtercharge auf die Stallluftqualität betrifft, lässt sich anhand einer Futtermittelanalyse auf Schimmel zuletzt oft nicht sagen.
Demgegenüber sind im sedimentierten Staub unglaublich viele Informationen über die hygienischen Verhältnisse in zurückliegender Zeit im Pferdestall gespeichert! Auch in Sachen Schimmel. Alles Feststoffliche, was sich einmal in der Stallluft befand, findet sich früher oder später größtenteils im sedimentierten Stallstaub wieder. Mit anderen Worten: Ist ein Pferdestall mit einem ernst zu nehmenden Schimmelproblem behaftet, lässt sich dieses Problem ohne weiteres anhand einer qualifizierten Prüfung des Stallstaubes auf entsprechende Indikatoren nachweisen.
Im Pferdestall gibt es unterschiedliche Arten eines Schimmelbefalls
Die häufigsten Schimmelpilzquellen im Pferdestall sind:
- feucht gewordene und verpilzte Einstreu
- verdorbenes Futter
- pilzbewachsener Stallstaub auf Oberflächen
- Schimmelpilzbefall an Stallbauteilen
Einstreu in Pferdeställen ist ebenso wie Rauhfutter generell und unvermeidbar mit Schimmelpilzen behaftet. Einstreu und Futter im Pferdestall sind schließlich organische Naturprodukte. Im Regelfall finden sich an „normal pilzbelastetem“ Einstreu- und Futtermaterial vorzugsweise ubiquitäre „Schwärzepilze“. Sehr dominant ist dabei die Schimmelpilz-Gattung Cladosporium. Untergeordnet finden sich an der Einstreu und am Futter Pilze der Gattungen Alternaria, Wallemia und andere „Schwärzepilze“. In länger feucht gehaltenem pflanzlichem Material kommt es nicht nur zur Massenvermehrung vorgenannter „Stall-typischer“ Pilze. Auch „Stall-untypische“ Pilze, von denen einige als für das Tier gefährliche Toxinproduzenten bekannt sind, können sich dann explosionsartig vermehren. Besonders häufig finden sich in verpilztem Material in Pferdeställen Schimmelpilze der Gattungen Aspergillus, Penicillium und Eurotium. Vgl. https://www.schimmelpilz-messungen.de/2017/07/06/in-der-umwelt-schimmelpilze-messen/
Im Pferdestall gibt es generell ziemlich viele Schimmelpilze
In jedem Pferdestall finden sich Schimmelpilze in der Luft. Im Regelfall misst man in Pferdeställen sogar recht hohe Schimmelpilzbelastungen. Viel höhere jedenfalls, als z.B. in Wohnräumen oder außen. Bei einer Stallstaubaufwirbelung und Bewegung, Kompression und Abrieb des organischen Futter- und Einstreumaterials, das sich in Pferdeställen befindet, gehen Schimmelpilze demgemäß und unvermeidbar in großer Zahl in die Luft über.
Bild 1 Schimmeltest im Pferdestall

Bild 1 Schimmeltest im Pferdestall
Abb.1: Älterer Sedimentstaub im Mikroskop beim Schimmeltest im Pferdestall, 40-fach optisch vergrößert. Der Staub besteht fast nur aus Schimmelpilzsporen und Myzelfragmenten von Schimmelpilzen
Die hohe „Hintergrundbelastung“ in Pferdeställen macht einen qualifizierten Schimmeltest mit den heute gängigen Kulturverfahren (z.B. Abklatsch, Sedimentationsplatten, Impaktions-Luftkeimsammler) unmöglich. Siehe hierzu https://www.advisan.net/testen-und-messen-von-schimmel-in-der-wohnung/. Die Mikroskopie ist in Pferdeställen das Schimmelpilz-Nachweisverfahren der Wahl.
Form der Sporen gibt entscheidende Hinweise auf die Quelle
Die Sporen der „Stall-typischen“ und „Stall-untypischen“ Pilze unterscheiden sich im Mikroskop sehr deutlich. Während die einen relativ groß, eher unregelmäßig geformt und sehr dunkel pigmentiert sind (daher übrigens die Bezeichnung „Schwärzepilze“), sind die anderen demgegenüber wesentlich kleiner und mehr oder weniger kugelig rund geformt.

Bild 2 Schimmeltest im Pferdestal
Abb.2: Frischer Sedimentstaub im Mikroskop beim Schimmeltest im Pferdestall, 40-fach optisch vergrößert. In dem Staub finden sich sehr viele Schimmelpilzsporen von „stalltypischen Schwärze-Schimmelpilzen“. Nicht pilzliche Stallstaubpartikel sind wenige zu finden. Hier gibt es ein Problem!

Bild 3 Schimmeltest im Pferdestall
Abb.3: Frischer Sedimentstaub im Mikroskop beim Schimmeltest im Pferdestall, 40-fach optisch vergrößert. In dem Staub finden sich weit überwiegend „Stall-untypische“ Schimmelpilzsporen der Form Aspergillus / Penicillium. Auch hier gibt es ein Problem, wahrscheinlich mit dem Futter.
Findet man im Stallstaub gehäuft „Stall-untypische“ Sporenformen, ist dies ein deutlicher Hinweis auf ein „Schimmelproblem“ durch verpilztes Futter oder durch einen Pilzbefall an Stallbauteilen. Oder weil sich viel zu viel Stallstaub angesammelt hat, der hygroskopisch ist, Feuchtigkeit bindet und z.B. von Aspergillus-Schimmelpilzen bewachsen wird. Findet man demgegenüber übermäßig viele „Stall-typische“ Pilze im Stallstaub (v.a. „Schwärzepilze“), gibt dies einen deutlichen Hinweis auf einen Schimmelpilzbefall in der Einstreu und / oder im Rauhfutter. Siehe hierzu auch https://www.schimmelpilz-messungen.de/2018/11/05/schimmel-im-pferdestall-messen/ .
Wie funktioniert der Schimmeltest im Pferdestall?
Die im sedimentierten Stallstaub enthaltenen Schimmelpilzsporen werden im Mikroskop gezählt. Nicht nur die Gesamtsporenzahl wird bestimmt. Auch das Sporenspektrum wird detailliert untersucht. „Stall-typische“ Sporen und „Stall-untypische“ Sporen werden jeweils separat bestimmt. Die jeweiligen Sporenzahlen der unterschiedlichen Typen werden ins Verhältnis zu den nicht-pilzlichen Stallstaubpartikeln in der Probe gesetzt. Um die ganzen Analysenergebnisse vernünftig auswerten zu können, muss man natürlich das Alter des untersuchten Stallstaubes genau kennen. Das macht man bei diesem Schimmeltest so:
Mit dem Test bekommt man zwei sterile Staubfangschalen zugeschickt, die zum Schimmeltest geöffnet einige Zeit in dem Stall aufgestellt werden. Je nach Staubaufkommen und Durchlüftung des Pferdestalls muss man etwa zwei bis fünf Sammeltage veranschlagen. Eine rein weiße Kontrollfläche innerhalb der Staubfangschale wird mit Staub beladen und verfärbt sich dunkel. Diese Fläche verrät, ob sich für eine Laborauswertung schon genug Stallstaub angesammelt hat, oder ob länger gemessen werden muss. Hierzu hält man eine farblich entsprechend abgetönte Referenzfläche, die sich in der Testsendung befindet, dagegen. Sobald genug Stallstaub gesammelt ist, nimmt man mit den beiden Tesa-Klebefilmstreifen in der Testpackung zwei Kontaktproben des Staubes von der Sammelfläche ab. Nach Rücksendung des Test-Kits wird der gesammelte Staub im Labor wie oben beschrieben mikroskopisch geprüft und die Sporen werden ausgezählt.
Sollte sich das vermutete „Schimmelproblem“ im Stall anhand der Messergebnisse bestätigen, kann unverzüglich die gezielte Quellenermittlung und -beseitigung eingeleitet werden. Dies ist im einfachsten Fall denkbar durch Austausch der Einstreu oder des Futters, kann im Einzelfall aber die Hinzuziehung eines qualifizierten Gutachters für Bauphysik oder labortechnische Futtermittelkontrollen erforderlich machen.
Zusammenfassung der Vorteile Schimmeltest im Pferdestall
Der Schimmeltest MYKOFUND-AGRAR zum selber machen im Pferdestall liefert belastbare Daten zur hygienischen Situation im Stall. Die Sedimentstaubprüfung implementiert überdies retrospektive Elemente in die hygienische Bestandsaufnahme. Sie gleicht auch kurzfristige Sporenbelastungsschwankungen im Stall aus. Die Prüfergebnisse sind dadurch mit einer größeren Belastbarkeit behaftet als beispielsweise aufwändige Prüfungen der momentanen Stallluftqualität mit Luftkeimsammlern. Kurz gesagt ist der Schimmeltest MYKOFUND-AGRAR ein vorgutachterliches und kostenoptimiertes Instrument zur Bestätigung eines konkreten Verdachtsmoments oder zum Ausschluss eines Schimmelproblems im Stall.
Inhalt und Leistungsumfang vom Schimmeltest für den Pferdestall:
- leicht verständliche Gebrauchsanleitung
- 2 sterile Spezial-Sammelschalen zur Stallstaubsammlung
- 2 Stück Klebefilm-Kontaktproben zur differenzierten Sporenzählung
- Porto und Versand des Schimmeltests zum Besteller
- Mikrobiologische Auswertung der Proben
- schriftlicher Prüfbericht mit Handlungsanweisung im gegebenen Fall

Bild 4 Schimmeltest im Pferdestall – Schimmeltest MYKOFUND-AGRAR
Anmerkung: Der Autor dieses Artikels, Dr. Thomas Missel, ist promovierter Mikrobiologe (Schwerpunkt: Mykologie), bereits 20 Jahre in Hannover und Niedersachsen als Gutachter tätig und bei der IHK Hannover Öffentlich bestellt und vereidigt als Sachverständiger (seit 2006). Bestellungsgebiet bei der IHK ist: Schimmelpilze und Feuchtigkeit in Innenräumen.
Fachliche Detailinformationen zum Thema „Schimmel im Pferdestall messen“:
https://www.schimmelpilz-messungen.de/2018/11/05/schimmel-im-pferdestall-messen/
Der Preis für den Schimmelpilztest MYKOFUND-AGRAR beträgt 76,90 Euro, dabei inklusive der Versandkosten zum Kunden und 19% MwSt.
Bestellung vorläufig per Email auf dem Kontaktformular dieser Seite oder per Mail direkt unter info@schimmelpilz-messungen.de
oder vorläufig telefonisch beim Labor für Arbeits- und Umwelthygiene unter 05139 – 9824 501
Bestellung im Onlineshop unter https://www.advisan.net/shop/